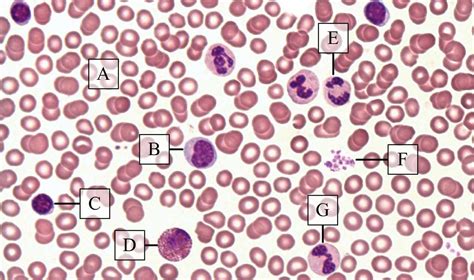
Vérsejtek mikroszkóppal

A terhesség alatti laborvizsgálatok alapvető szerepet játszanak az anya és a magzat egészségének ellenőrzésében, valamint a terhesség során fellépő szövődmények megelőzésében. Segítségükkel időben felismerhetők azok az eltérések, amelyek veszélyeztethetik a várandósságot, így lehetőség nyílik a korai beavatkozásra és a megfelelő kezelésre. Ezek a vizsgálatok lehetővé teszik többek között a terhességi cukorbetegség, vérszegénység, magas vérnyomás, fertőzések és hormonális egyensúlyzavarok azonosítását, amelyek befolyásolhatják a magzat fejlődését és a terhesség kimenetelét. Emellett a laborvizsgálatok segítségével kiszűrhetők bizonyos genetikai rendellenességek, valamint a véralvadási problémák, amelyek növelhetik a vetélés vagy koraszülés kockázatát. A rendszeres laborvizsgálatok tehát nemcsak a várandós anya egészségét védik, hanem hozzájárulnak a magzat biztonságos fejlődéséhez is, így elengedhetetlenek a komplikációmentes terhesség érdekében.
A HCG hormon: a terhesség kulcsfontosságú markere
A humán chorion gonadotropin (hCG) egy hormon, amelyet a placenta termel a terhesség alatt. A

A Beta hCG teszt egy kritikus diagnosztikai eszköz, amelyet elsősorban a terhesség megerősítésére és bizonyos egészségügyi állapotok diagnosztizálására használnak. Ez a vérvizsgálat a humán chorion gonadotropin (hCG) szintjét méri. A Beta hCG teszt a hCG hormon béta alegységét méri, amely specifikus és pontos információkat nyújt. A hormon általában röviddel azután termelődik, hogy a megtermékenyített petesejt a méhnyálkahártyához tapad. A teszt rendkívül pontos a terhesség kimutatására és a hCG-vel kapcsolatos állapotok nyomon követésére.
A vizelettesztek széles körben kaphatóak. A terhességi teszt kétféle lehet: kémcsöves - kétórás - és tesztcsíkos - pár perces. A gyógyszertári tesztek pontossága elég jó, bár közel sem 100%-os. A két határozott csík (általában) terhességet jelent. A teszt pozitivitása esetén mindig célszerű nőgyógyászhoz fordulni és megerősíteni ultrahang vizsgálattal a terhesség tényét. A vizeletből történő terhességi hormon kimutatásnál sokkal érzékenyebb módszer a vér vizsgálata. A terhesség korai szakaszában, alacsony hormonszint mellett is megállapítható a várandóság ténye.
A HCG mint a terhesség jele: a HCG megjelenése, szintjének emelkedése a vizeletben és a vérben. A terhesség első heteiben rohamosan nő a HCG szint a vérben - ez a terhességi tesztek működésének az alapja - a maximumát a 10-12. terhességi héten éri el. A drogériákban kapható terhességi tesztek érzékenysége különböző, így a petesejt megtermékenyülése után más-más időpontokban képesek nagy hatékonysággal kimutatni a magas HCG szintet a vizeletből. A legtöbb kb. 25 nemzetközi egység/liter érzékenységű, általában a menstruáció elmaradásának napján, vagy utána pár nappal már nagy biztonsággal használható.
A terhesség alatti laborvizsgálatok szakaszai
Első trimeszter: Alapvető vizsgálatok az egészséges kezdetért
Az első trimeszterben végzett laborvizsgálatok célja a kismama egészségi állapotának felmérése, valamint azoknak a tényezőknek a kiszűrése, amelyek hatással lehetnek a magzat fejlődésére. Az alábbi laborvizsgálatok segítenek az esetleges szövődmények időben történő felismerésében és megelőzésében.
Alapvető vérvizsgálatok
A teljes vérkép vizsgálata elengedhetetlen, mivel információt ad a vérszegénységről (hemoglobin- és hematokritszint), a fehérvérsejtszámról (fertőzés vagy gyulladás jelenléte), valamint a vérlemezkék állapotáról (véralvadási problémák kizárása).
Vércsoport és Rh-faktor meghatározása
A vércsoport és az Rh-faktor ismerete alapvető fontosságú, mivel Rh-negatív anyák esetében fennáll az Rh-összeférhetetlenség veszélye, ha a magzat Rh-pozitív. Ez immunreakciót válthat ki, amely befolyásolhatja a magzat fejlődését, és korai beavatkozást igényelhet.
Vas- és B12-vitamin szint ellenőrzése
A vas és B12-vitamin szintjének vizsgálata segít az anaemia (vérszegénység) és az idegrendszeri fejlődést érintő hiányállapotok időben történő felismerésében. A terhesség során fokozott a szervezet vas- és B12-szükséglete, ezért ezek az értékek kiemelt jelentőséggel bírnak.
Vércukorszint és inzulinrezisztencia vizsgálat
A vércukorszint mérése az első trimeszterben segíthet a cukorbetegség vagy inzulinrezisztencia azonosításában, amelyek befolyásolhatják a terhesség lefolyását és a magzat fejlődését. Az orvos javasolhatja az inzulinrezisztencia vizsgálatot is, különösen, ha a kismama túlsúlyos, PCOS-sel diagnosztizálták, vagy korábbi terhessége során gesztációs diabétesz fordult elő.
Vizeletvizsgálat
A terhesség alatti vizeletvizsgálat segít az egyes fertőzések, fehérjeürítés (preeklampszia kockázata) és a cukorbetegség (glükóz jelenléte a vizeletben) korai felismerésében. A húgyúti fertőzések terhesség alatt tünetmentesek is lehetnek, viszont kezeletlenül vetéléshez vagy koraszüléshez vezethetnek, ezért a rendszeres vizeletvizsgálat kiemelten fontos.
Fertőző betegségek szűrése
A terhesség alatt bizonyos fertőzések súlyos következményekkel járhatnak a magzatra nézve, ezért az alábbi kórokozók jelenlétét laboratóriumi vizsgálatokkal ellenőrzik: HIV, Hepatitis B és C, szifilisz, rubeola - ezek a fertőzések az anya szervezetéből a méhlepényen keresztül átjuthatnak a magzathoz, súlyos fejlődési rendellenességeket vagy akár vetélést okozva. Toxoplasma gondii és cytomegalovírus (CMV) - ezek a fertőzések a magzat idegrendszeri fejlődését veszélyeztethetik, különösen, ha az anya először találkozik velük a terhesség során.
Pajzsmirigy működés ellenőrzése
A pajzsmirigy hormonjai (TSH, T3, T4) kiemelten fontosak a magzat idegrendszeri és anyagcsere-fejlődésében, ezért a várandósság alatt ellenőrizni kell szintjüket. A TSH szintjének emelkedése vagy csökkenése negatívan befolyásolhatja a magzat fejlődését, ezért a pajzsmirigy-alulműködés és túlműködés egyaránt fokozott figyelmet igényel. Az anti-TPO antitestek vizsgálata segít az autoimmun pajzsmirigybetegségek felismerésében, amelyek befolyásolhatják a terhesség kimenetelét és a magzat fejlődését.
Második trimeszter: Folyamatos ellenőrzés és szűrések
A második trimeszter laborvizsgálatai a kismama egészségének folyamatos ellenőrzésére és a magzat fejlődésének nyomon követésére szolgálnak. Ebben az időszakban kiemelt figyelmet kap a gesztációs diabétesz, a vérszegénység, a genetikai eltérések szűrése és a fertőzések kizárása.
Terheléses vércukorvizsgálat (OGTT)
A 24-28. terhességi hét között végzett terheléses vércukorvizsgálat (OGTT) célja a gesztációs diabétesz, azaz a terhességi cukorbetegség felismerése. A vizsgálat során először éhgyomorra, majd glükóz elfogyasztását követően 60 és 120 perccel újabb vérmintákat vesznek.

AFP és kombinált tesztek (Down-szindróma és egyéb genetikai rendellenességek szűrése)
Az alfa-fetoprotein (AFP) egy olyan fehérje, amelyet a magzat mája termel, és amelynek szintjét az anya vérében mérik. Az AFP szint eltérései utalhatnak nyitott gerincre (spina bifida), egyéb fejlődési rendellenességekre vagy bizonyos genetikai betegségekre. A kombinált genetikai szűrések, például a négyes teszt (AFP, hCG, ösztriol, inhibin-A) további információt adhatnak a Down-szindróma (Trisomia 21) és más kromoszóma-rendellenességek kockázatáról. Ezek a vizsgálatok nem adnak végleges diagnózist, de segítenek kiszűrni azokat az eseteket, ahol további, részletesebb genetikai vizsgálatok szükségesek.
Vashiány és vérszegénység ellenőrzése
A terhesség alatt a szervezet vasigénye jelentősen megnő, mivel a magzat vérképzéséhez is szükség van rá. A hemoglobinszint csökkenése vérszegénységre (anaemia) utalhat, amely fáradtságot, szédülést, sápadtságot és a magzat fejlődésének lassulását okozhatja. A ferritin a szervezet vasraktárait mutatja, míg a transzferrin szaturáció a vas felszívódásának hatékonyságát jelzi. A terhességi vérszegénység megelőzése érdekében az orvos megfelelő étrendet vagy szükség esetén vaskészítmények szedését javasolhatja.
Máj- és vesefunkciók ellenőrzése
A máj és a vese működésének rendszeres ellenőrzése segít időben felismerni a terhesség alatt esetlegesen kialakuló eltéréseket, például a májbetegségeket, mint az intrahepatikus kolesztázis, vagy a vesekárosodást, amely a terhességi toxémia egyik figyelmeztető jele lehet. A vizsgálatok során a GOT és GPT májenzimek szintjét mérik, amelyek a máj működését jelzik. A vese szűrőképességének ellenőrzésére a kreatinin- és GFR-szinteket vizsgálják, mivel ezek az értékek a várandósság alatt természetes módon is változhatnak.
Fertőzések szűrése - Streptococcus B és egyéb baktériumok
A Streptococcus B (GBS) fertőzés a hüvely normál flórájában is előfordulhat, de szülés közben a magzatra átterjedve súlyos újszülöttkori fertőzéseket okozhat, például tüdőgyulladást vagy agyhártyagyulladást. A második trimeszterben végzett szűrés segít azonosítani a baktérium jelenlétét, és pozitív eredmény esetén az anya szülés alatt antibiotikumot kaphat a fertőzés megelőzésére. Ezen kívül egyéb hüvelyi és húgyúti fertőzések (például Chlamydia, gonorrhoea, bakteriális vaginózis) vizsgálata is ajánlott lehet, mivel ezek növelhetik a koraszülés és magzati fertőzés kockázatát.
Harmadik trimeszter: Záró laborvizsgálatok a biztonságos szülésért
A harmadik trimeszterben végzett laborvizsgálatok célja a kismama és a magzat egészségének ellenőrzése a szülés előtti időszakban. Ezek a tesztek segítenek az esetleges szövődmények, például a vérszegénység, fertőzések, véralvadási problémák és terhességi toxémia felismerésében, így biztosítva a szülés minél biztonságosabb lefolyását.
A teljes vérkép ismételt ellenőrzése
A teljes vérkép ismételt ellenőrzése fontos annak érdekében, hogy kizárják a vérszegénységet, fertőzéseket vagy trombocitaszám eltéréseket. Az alacsony hemoglobinszint vérszegénységre utalhat, míg a túlzottan magas vagy alacsony fehérvérsejtszám fertőzés jelenlétére figyelmeztethet. A trombocitaszám csökkenése véralvadási problémákat jelezhet, amelyek befolyásolhatják a szülés menetét.
HIV és Hepatitis B újratesztelés
Bizonyos esetekben szükség lehet a HIV és Hepatitis B újratesztelésére, különösen akkor, ha a kismama fokozott kockázati csoportba tartozik, vagy korábban nem történt meg ezeknek a betegségeknek a szűrése. Az újszülött védelme érdekében ezek az ellenőrzések kiemelten fontosak.
Vizeletvizsgálat a preeklampszia szűrésére
A vizeletvizsgálat a preeklampszia és a terhességi toxémia felismerésében játszik szerepet. A vizeletben megjelenő fehérje a preeklampszia egyik figyelmeztető jele lehet, amely magas vérnyomással együtt komoly szövődményeket okozhat. Az időben történő felismerés lehetőséget ad a megfelelő kezelésre, amely segíthet a súlyos következmények, például a koraszülés vagy a méhlepény elégtelen működésének megelőzésében.
Alvadási faktorok vizsgálata
A szülés előtt szükséges az alvadási faktorok vizsgálata is, amely a véralvadás folyamatát értékeli. A PT, INR és APTT tesztek eredményei információt adnak arról, hogy a kismama szervezete megfelelően reagál-e a szülés során fellépő vérzésekre. Az eltérések véralvadási problémákra utalhatnak, amelyek befolyásolhatják a hüvelyi szülés vagy császármetszés menetét, valamint az érzéstelenítés biztonságosságát.
Genetikai laborvizsgálatok terhesség alatt
A terhesség alatt végzett genetikai laborvizsgálatok célja a magzat egészségi állapotának felmérése és bizonyos genetikai eltérések kizárása. Ezek a vizsgálatok különösen ajánlottak bizonyos kockázati tényezők fennállása esetén, például ha az anya életkora meghaladja a 35 évet, a családban előfordult genetikai betegség, vagy az ultrahangvizsgálatok során eltérések mutatkoznak.
A non-invazív prenatális teszt (NIPT) egy modern vérvizsgálati módszer, amely az anya vérében keringő magzati DNS elemzésével azonosítja a Down-szindrómát (Trisomia 21), Edwards-szindrómát (Trisomia 18) és Patau-szindrómát (Trisomia 13).

Ha a NIPT vagy egyéb szűrővizsgálatok eredményei eltérést mutatnak, az orvos invazív genetikai vizsgálatokat, például amniocentézist vagy chorionboholy-mintavételt (CVS) javasolhat. Az amniocentézis során magzatvíz-mintát vesznek, amely részletesebb genetikai elemzést tesz lehetővé. Bár ezek a vizsgálatok pontosabbak, kis mértékben növelhetik a vetélés kockázatát, ezért csak akkor alkalmazzák őket, ha a kockázatok indokolják.
Hogyan zajlanak és hogyan készüljünk fel a terhességi laborvizsgálatokra?
A terhesség során végzett laborvizsgálatok több alkalommal is szükségesek, hogy az orvos folyamatosan nyomon követhesse az anya és a magzat egészségi állapotát. A vérvétel az egyik legfontosabb diagnosztikai módszer, amelyet a várandósság különböző szakaszaiban végeznek. Általában 4-6 alkalommal kell vért venni a terhesség során, de ha az orvos szükségesnek látja, ennél gyakoribb ellenőrzések is történhetnek.
A vizeletvizsgálat szintén elengedhetetlen része a terhességi ellenőrzéseknek. A fehérje- és glükózszintek ellenőrzése segít kiszűrni a preeklampsziát és a terhességi cukorbetegséget, míg a fertőzések kimutatása a húgyúti betegségek megelőzésében játszik szerepet. A vizeletmintát általában reggeli első vizeletből kell leadni, mivel ez a legkoncentráltabb, és így a legmegbízhatóbb eredményt adja.
Bizonyos vizsgálatok, például a vércukorszint és a lipidprofil mérése éhgyomorra történik, ezért ezeket reggel, legalább 8-12 órás koplalás után kell elvégezni. Más vizsgálatok, például a teljes vérkép vagy a pajzsmirigyhormonok ellenőrzése nem igényel éhgyomri állapotot. Az étrend befolyásolhatja a vérvizsgálati eredményeket, különösen a cukor- és koleszterinszinteket. A laborvizsgálat előtti napokban ajánlott kerülni a zsíros, cukros ételeket, a túlzott koffeinfogyasztást és az alkoholt, hogy a kapott eredmények a valós állapotot tükrözzék.
A gyógyszerek és vitaminok hatással lehetnek egyes laborértékekre. Például a vastartalmú készítmények befolyásolhatják a vasszintet, míg bizonyos pajzsmirigygyógyszerek megváltoztathatják a hormoneredményeket. Ezért érdemes az orvossal egyeztetni, hogy a laborvizsgálat előtt szükséges-e egyes gyógyszerek vagy étrend-kiegészítők átmeneti kihagyása. A megfelelő előkészületekkel biztosítható, hogy a laborvizsgálatok pontos és megbízható eredményt adjanak, így hozzájárulva a kismama és a magzat egészségének megőrzéséhez.
Mit jelentenek az eltérések a laboreredményekben?
A terhesség során végzett laborvizsgálatok célja a kismama és a magzat egészségének folyamatos nyomon követése. Az eredményekben tapasztalt eltérések nem minden esetben jelentenek betegséget, azonban fontos, hogy az orvos értékelje azokat, és szükség esetén további vizsgálatokat vagy kezelést javasoljon.
Vashiány és vérszegénység kezelése
A várandósság alatt a szervezet vasigénye megnő, mivel a magzat vérképzéséhez is szükség van rá. Ha a hemoglobin- vagy ferritinszint alacsony, az vashiányos vérszegénységre utalhat, amely fáradtságot, szédülést, fejfájást és sápadtságot okozhat. Kezelésként az orvos vasban gazdag étrendet és szükség esetén vaspótló készítményeket javasolhat. Súlyos esetekben vénás vaspótlásra is szükség lehet.
Terhességi cukorbetegség (gesztációs diabétesz) diagnózisa
A terheléses vércukorvizsgálat (OGTT) során mért emelkedett vércukorszint gesztációs diabéteszre utalhat, amely a terhesség alatt kialakuló szénhidrát-anyagcsere zavart jelent. Kezeletlen esetben növelheti a magzati túlnövekedés, a koraszülés és a szülési komplikációk kockázatát. Az orvos egyénre szabott diétát, rendszeres vércukorszint-ellenőrzést és szükség esetén inzulinkezelést javasolhat a megfelelő vércukorszint fenntartása érdekében.
Pajzsmirigyproblémák terhesség alatt
A pajzsmirigy hormonjai kiemelten fontosak a magzat fejlődésében. A TSH szintjének eltérései, vagy az autoimmun pajzsmirigybetegségek (pl. anti-TPO antitestek) befolyásolhatják a terhesség kimenetelét és a magzat fejlődését. Kezeletlen pajzsmirigybetegség esetén vetélés, koraszülés, születési rendellenesség vagy terhességi toxémia is kialakulhat.
A Pajzsmirigy Alulműködés korai tünetei, okai + a megoldások
tags: #hematokrit #es #hcg #vervetel